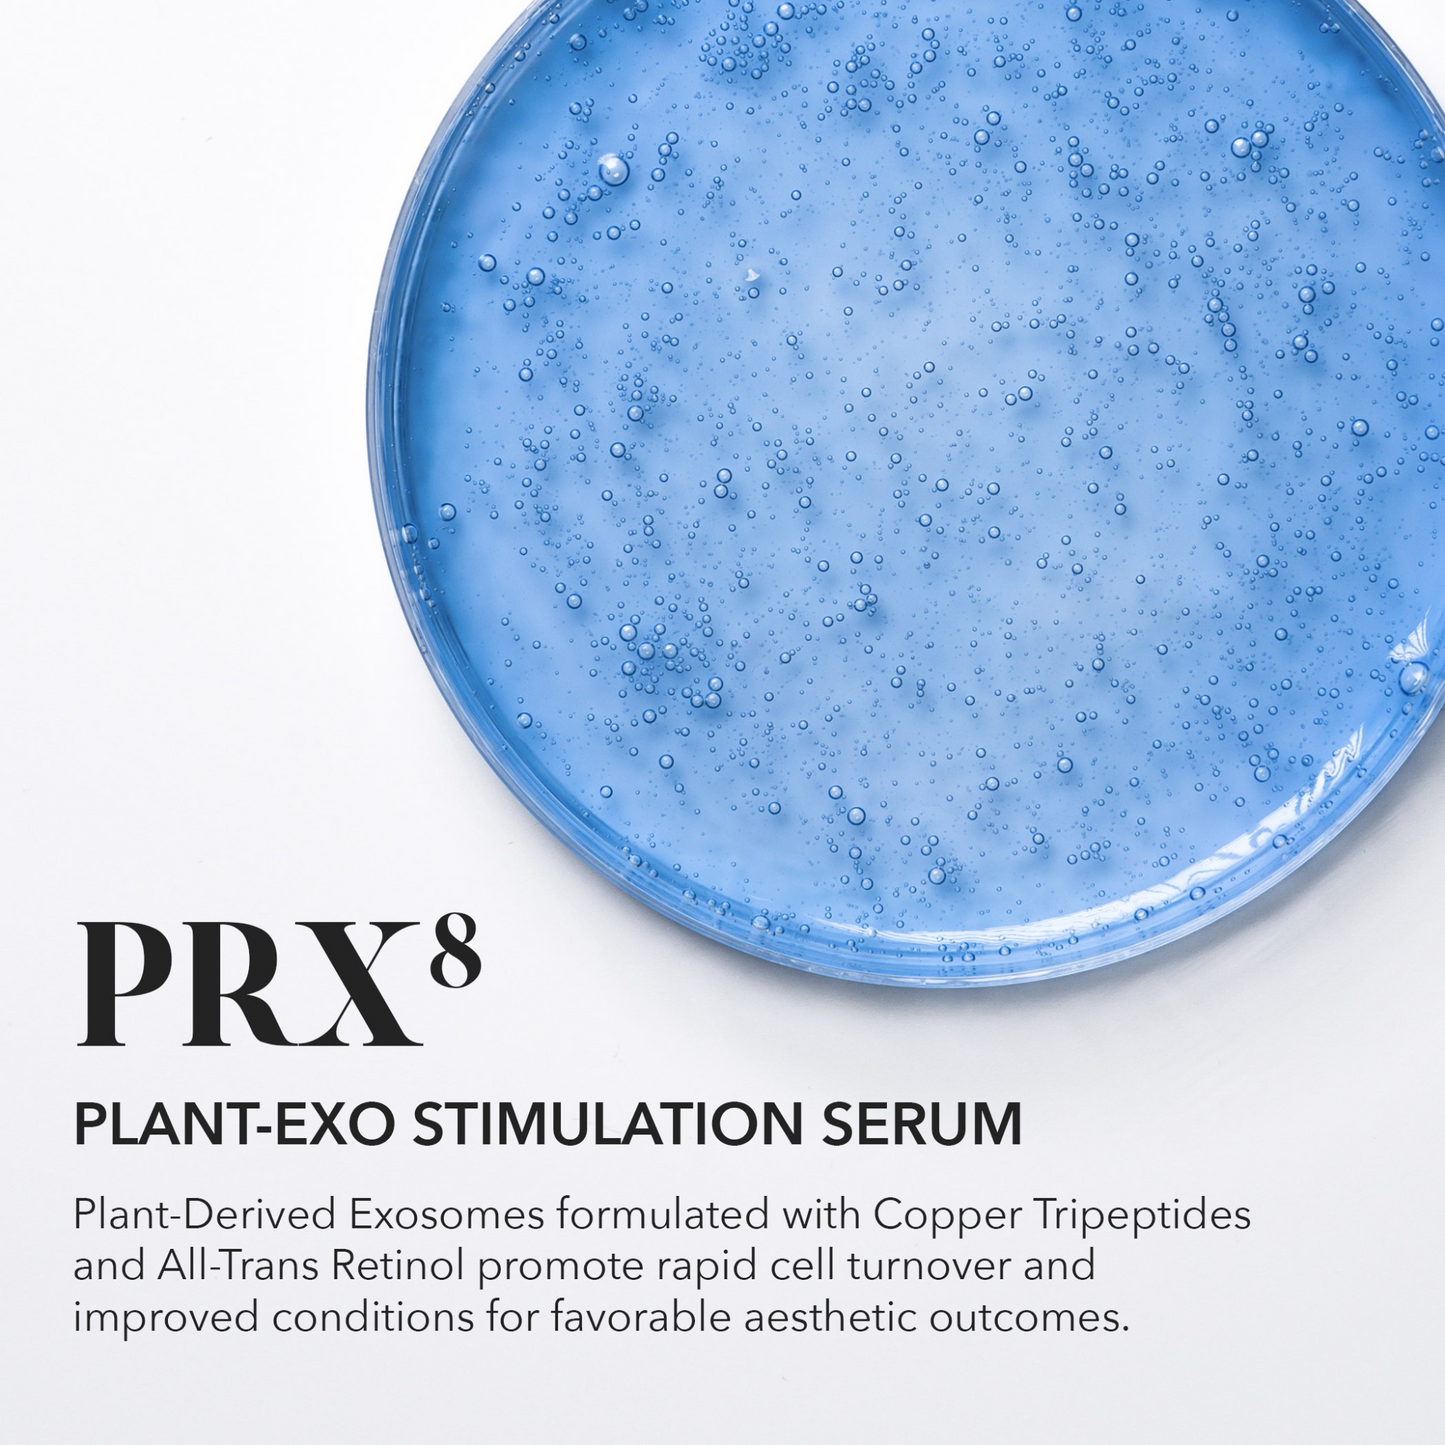

Professional Use Only
PRX⁸ Plant-Exo Stimulation Serum (single)
PRX⁸ Plant-Exo Stimulation Serum (single)
Regular price
$125.00 USD
Regular price
Sale price
$125.00 USD
Unit price
per
Description
Plant-Exosome Enhanced Collagen Stimulation Serum
Plant-derived Exosomes, Copper Tripeptides and All-Trans Retinol combine to stimulate conditions for rapid cell renewal and improved results for a variety of aesthetic treatments.

Related Products
Complete your skincare lineup with these complementary products, carefully curated to enhance your routine and deliver optimal results.